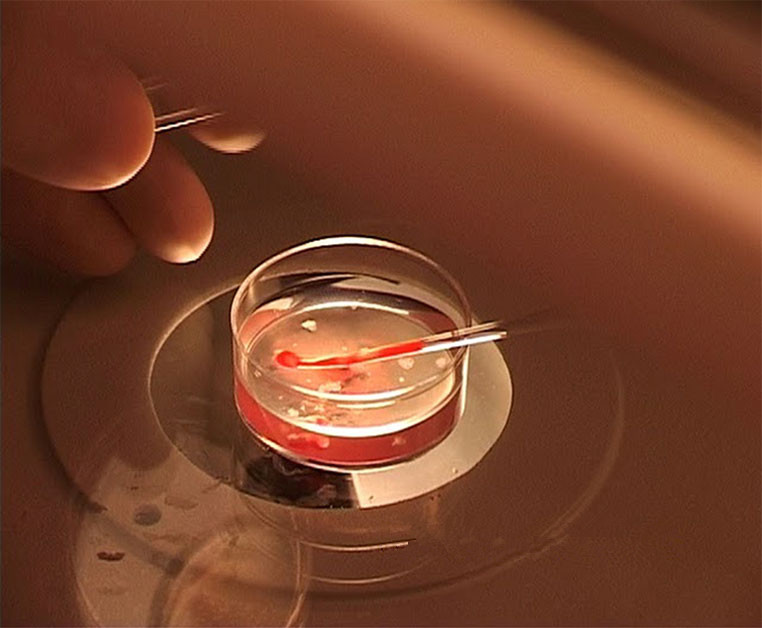

第二代试管婴儿(ICSI)的主要过程
第二代试管婴儿(ICSI)的主要过程如下:
- 使用促排卵药物刺激卵巢,让多枚卵泡同时成熟和脱落
- 将促排后得到的卵子取出来等待受精
- 处理精液,分离出精子细胞用于与卵子体外受精
- 使用IMSI 技术在高倍显微镜下挑选精子用于单精子注入
- 使用ICSI技术让精子和卵子在实验室内受精结合成胚胎
- 在实验室内培养胚胎,直至胚胎发育到适合着床的阶段
- 将胚胎移植回子宫内
- 移植后的剩余胚胎冷冻处理
第一步,卵子促排
在月经的第二或第三天,通过抽血化验检查女性体内性激素,评估卵巢功能,然后通过阴道超声波观察此次月经周期产生的基础卵泡数量。为了让多枚卵子同时成熟脱落,一般使用注射型的促排卵药物。促排方案有很多种,泰国Phyathai Sriracha 医院试管婴儿中心采用的是统一的促排方案,优点是促排过程简易,促排效果好。
促排方案为:在月经的第二或第三天通过抽血化验检查女性体内性激素,评估卵巢功能。医生根据血液检查结果、超声波检查结果,再结合女性的年龄,为患者开适量的促排卵药物,在当天开始注射。促排卵药物的种类大概分为2-3 种,第一种“重组FSH促卵泡生长激素”(Recombinant FSH) ,其作用是让多枚卵泡同时发育;约在第5 天注射第二种药物“GnRH 拮抗剂 ”(GnRH antagonist) 防止卵子在取卵前脱落;促排卵药物一共注射时间约为10-12天,在此期间通过检查荷尔蒙和超声波监测卵泡的发育, 检查次数约为三次。最后通过测量卵泡大小来确定取卵日期,卵泡最少要达到18 mm 才适合取卵。确定取卵日期后注射破乱针 (hCG) ,让卵子在36 小时后成熟和脱落。

促排时间表

上图所展示的是国外进口的促排卵药物,产商不同,效果相近,价格有所区别
第二步,取卵
取卵的过程是在静脉无痛全麻的情况下,经阴道B超引导,取卵针穿过阴道穹窿,直达卵巢吸取卵子。整个过程患者处于睡眠状态,无疼痛感,医生在超声波的辅助下找到卵子,取卵时间不超过半个小时。使用显微镜从取出的液体中挑出卵子,然后将卵子移到培养液中,等待与精子受精。受精。

通过超声波引导下从阴道取卵,在吸取卵子后,卵泡萎缩,从卵泡内取到的液体和卵子被吸入取卵瓶中,这些液体被送到培养室用于查找卵子。
第三步,分离精子
男性在取精之前应该禁欲三天,但是不超过七天,采用手淫的方式取精。取精时使用试管婴儿专用的无菌杯,取精后半小时之内精液必须送至实验室进行精子分离处理,如果超过时间会降低精子与卵子的受精结合能力。经过分离挑选的精子在特殊的营养液中培养,增加其运动速度,提高受精结合能力。

精子的处理包括:使用密度梯度液的连续梯度离心法,收集沉淀下来的有生命力的精子,用于和卵子受精
第四步,挑选精子用于ICSI
在进行卵浆内单精子注入前需要从处理过的精子中再次挑选最有机会受精的精子用于注入卵内,一般使用IMSI或其他技术,详情请点击这里
第五步,卵浆内单精子注入受精
对于男性精子数量和质量低于标准的患者,如果将精子和卵子放在一起使其自行受精,精子和卵子不结合的风险很高,所以对于少精弱精的问题,应该采用第二代试管婴儿ICSI技术辅助受精,才能够得到更多的胚胎。挑选最有可能授精的精子,用微型针管将一个精子注入到一个卵子内。

第六步,胚胎培养
在温度适宜的胚胎培养箱内培养胚胎,使其能够从一个细胞依次分裂为两个、四个、八个细胞,此时的胚胎可以挑选移植回子宫,也可以继续培养使其发育至囊胚期胚胎 (Blastocyst)

第七步,胚胎移植
胚胎移植手术和一般的妇科检查相似,患者不需要任何麻醉或催眠,除非少数患者出现无法将医疗器具放入阴道或过于紧张焦虑,可使用安眠的药物,有助于胚胎移植的顺利完成。胚胎移植是采用非常细的胚胎移植管,将胚胎吸入管内,然后经过子宫口将胚胎放置于子宫内膜上。移植过程中使用超声波协助观察,有利于将胚胎放置在最合适的位置。因为每个女性的子宫内部结构不一样,相对于不使用超声波协助的胚胎移植,使用超声波协助的成功怀孕的机会更高。
第八步,胚胎冷冻
胚胎冷冻技术,是现代试管婴儿成功率得以提高的关键。胚胎冷冻技术经过不断的发展完善,冷冻时间可长达多年,患者在多年后移植冷冻胚胎也同样有机会受孕,不需要重新促排。如果移植冷冻胚胎,女性内膜厚度与自然内膜相近,而移植新鲜胚胎,因为有促排卵药物的影响,可能会出现内膜过厚的问题,不适合胚胎的着床。所以相比较之下,对于促排后的卵子数量较多的患者,胚胎冷冻移植的成功率有可能高于新鲜移植。

上图展示在液态氮气环境下冷藏胚胎,其温度为零下196 摄氏度
胚胎的冷冻方法有很多种,在Phyathai Sriracha医院试管婴儿中心主治医生“SUCHADA医生”采用的是“胚胎玻璃化保存”方法,能够自行配制冷冻时使用的培养液,不需要依靠进口。胚胎冷冻经验长达十年,胚胎解冻后的成活率高达95%,解冻后的胚胎能发育到囊胚期的机会与新鲜胚胎无异。所以可以为患者提供胚胎的新鲜移植(指在取卵后就直接移植胚胎)和冷冻移植,而且因为冷冻技术几乎不影响胚胎质量,又能够得到最适合的内膜厚度,所以冷冻移植比新鲜移植的成功率要高。

关注试管婴儿官方微信帐号:"Y400-066-9158",每日早晚,获取最新试管婴儿资讯。
下一篇: 男性患有无精症能做第二代试管婴儿吗
上一篇:第二代试管婴儿ICSI简介
立即申请"泰国试管婴儿优惠礼包"
每天公开放10个免费名额
余最后10个名额
网络直接申请试管婴儿套餐
送试管婴儿助孕金3000元
- 秦*生领取礼包成功2016-07-23
- 冯*士领取礼包成功2016-07-23
- 马*红领取礼包成功2016-07-23
- 聂*丽领取礼包成功2016-07-08
- 卢*领取礼包成功2016-07-08
- li*y领取礼包成功2016-07-08
- 邵*宁领取礼包成功2016-06-28
- 梁*悦领取礼包成功2016-06-28
- 蔡*士领取礼包成功2016-06-25
- 李*蔷领取礼包成功2016-06-25
- 曹*娟领取礼包成功2016-06-25
- 樊*晓领取礼包成功2016-06-22
- 李*楠领取礼包成功2016-06-22
- 赵*兰领取礼包成功2016-06-22
- 何*娇领取礼包成功2016-05-25
- 张 *领取礼包成功2016-05-25
- 曹*霞领取礼包成功2016-05-23
- 李*梦领取礼包成功2016-05-16
- 张*珺领取礼包成功2016-05-16
- 王*芳领取礼包成功2016-05-14
- 谭*鑫领取礼包成功2016-05-14
- 穆*龙领取礼包成功2016-05-14
- 方*球领取礼包成功2016-05-13
- 丁*慧领取礼包成功2016-05-13
- 陈*仙领取礼包成功2016-05-13
- 秦*子领取礼包成功2016-05-13
- 洪*兰领取礼包成功2016-05-13
- 杜*生领取礼包成功2016-05-12
- 赵*士领取礼包成功2016-05-12
- 韩*娟领取礼包成功2016-05-12
- 林*子领取礼包成功2016-05-11
- 梁*妹领取礼包成功2016-05-11
- 张*强领取礼包成功2016-05-11
- 文*霞领取礼包成功2016-05-11
- 秦*士领取礼包成功2016-05-11
- 李*花领取礼包成功2016-02-27
- 袁*娟领取礼包成功2016-02-15
- 胡*品领取礼包成功2016-02-15
- 陈*勋领取礼包成功2016-02-15
- 喻*连领取礼包成功2016-02-15
- 秦*生领取礼包成功2016-07-23
- 冯*士领取礼包成功2016-07-23
- 马*红领取礼包成功2016-07-23
- 聂*丽领取礼包成功2016-07-08
- 卢*领取礼包成功2016-07-08
- li*y领取礼包成功2016-07-08
- 邵*宁领取礼包成功2016-06-28
- 梁*悦领取礼包成功2016-06-28
- 蔡*士领取礼包成功2016-06-25
- 李*蔷领取礼包成功2016-06-25
- 曹*娟领取礼包成功2016-06-25
- 樊*晓领取礼包成功2016-06-22
- 李*楠领取礼包成功2016-06-22
- 赵*兰领取礼包成功2016-06-22
- 何*娇领取礼包成功2016-05-25
- 张 *领取礼包成功2016-05-25
- 曹*霞领取礼包成功2016-05-23
- 李*梦领取礼包成功2016-05-16
- 张*珺领取礼包成功2016-05-16
- 王*芳领取礼包成功2016-05-14
- 谭*鑫领取礼包成功2016-05-14
- 穆*龙领取礼包成功2016-05-14
- 方*球领取礼包成功2016-05-13
- 丁*慧领取礼包成功2016-05-13
- 陈*仙领取礼包成功2016-05-13
- 秦*子领取礼包成功2016-05-13
- 洪*兰领取礼包成功2016-05-13
- 杜*生领取礼包成功2016-05-12
- 赵*士领取礼包成功2016-05-12
- 韩*娟领取礼包成功2016-05-12
- 林*子领取礼包成功2016-05-11
- 梁*妹领取礼包成功2016-05-11
- 张*强领取礼包成功2016-05-11
- 文*霞领取礼包成功2016-05-11
- 秦*士领取礼包成功2016-05-11
- 李*花领取礼包成功2016-02-27
- 袁*娟领取礼包成功2016-02-15
- 胡*品领取礼包成功2016-02-15
- 陈*勋领取礼包成功2016-02-15
- 喻*连领取礼包成功2016-02-15